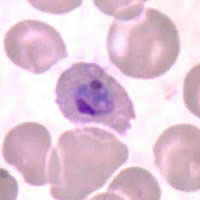
Case 62 Image A
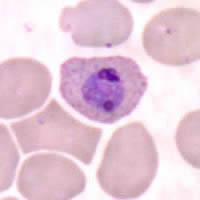
Case 62 Image B
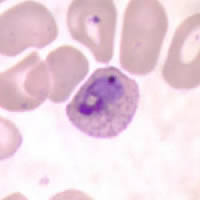
Case 62 Image C
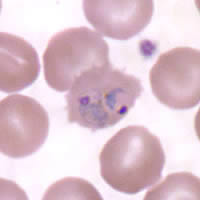
Case 62 Image D
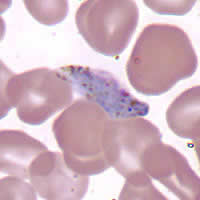
Case 62 Image F
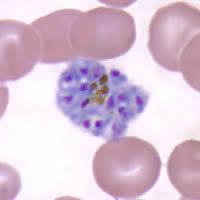
Case 62 Image G
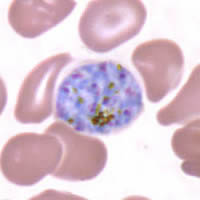
Case 62 Image I

|
Case
61
A male CDC employee had diarrhea for six weeks before consulting the occupational
health clinic. He had traveled to several different African countries
a few weeks prior. His symptoms included abdominal cramps and frothy
stools. The man treated himself with metronidazole without improvement.
A stool specimen preserved in zinc polyvinyl alcohol (Zn-PVA) was submitted
to the reference laboratory for diagnostic evaluation. Smears were
made from the specimen, stained with trichrome, and examined. The
QuickTime movie clip (Figure A) below shows an example of cyst-like
organisms, averaging 13 to 14 micrometers in diameter, that were found
in moderate numbers in the trichrome stained smear. The movie clip
simulates focusing through several planes when you move the slider control
of your viewer back and forth. Figures B and C
show examples of a different stage of the same or similar organisms,
averaging 15 to 16 micrometers in diameter. What is your diagnosis?
Based on what criteria?
QuickTime
is required to view the movie clip. If you do not have QuickTime
5.0 or greater, you can download it free from http://www.apple.com/quicktime/download/.
![Case 61 Video A]() |
| A |
After the
video clip plays through one time, you can right click on the image and
choose play to watch the video again.
 |
 |
| B |
C |
Click
here for the answer to Case 61.
Case
62
An adult female was diagnosed with malaria. Her travel history included trips to
Ghana and Sierra Leone. The hospital laboratory consulted CDC after
getting clearance from the state health department for assistance in identifying
the species responsible for this case. The original blood smears
were sent to CDC along with whole blood in EDTA for confirmation.
What is your diagnosis? Based on what criteria?
|
|
| A |
B |
|
|
| C |
D |
 |
|
| E |
F |
|
 |
| G |
H |
|
| I |
Click
here for the answer to Case 62.
|